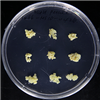

Korean Collection for Type Cultures
KCTC에서는 일반자원 분양과 특허자원 분양 서비스를 제공 합니다.
Distribution
분양
KCTC PC1066
| KCTC No. | PC1066 |
|---|---|
| KCTC No. (old) | |
| LMO | false |
| Resource Type | plant cell line |
| Family Name | |
| Name | Oenanthe javanica |
| Korean Name | 미나리 |
| Plant Cell Powder | |
| Synonym | |
| History | 김석원 |
| Other Collection No. | BP1421862 |
| Source | Petiole |
| Products | |
| Application | |
| Temperature | 25 ℃ |
| KCTC Media No. |
KCTC media No. 1312 MS1D |
| Culture Morphology | Callus |
| Embryo Genic | |
| Light Require | Dark |
| ABTS Activity (90%) | |
| DPPH Activity (90%) | |
| SOD Activity (90%) | |
| Images |
|
| Price | ₩ 100000 |
| MTA Restrictions | Only NON-COMMERCIAL USE for reference strains and/or academic researches |
* KCTC에서 분양받은 자원을 이용하여 논문이나 특허에 사용하실 경우, ‘본 연구에 사용된 생물자원은 KCTC로부터 제공받았음’ 문구를 반드시
기재해주시기 바랍니다.
(영문 : The biological resources used in this research were distributed from KCTC.)
 MICROBIOTA
MICROBIOTA







 담당자
담당자 기탁/분양서류
기탁/분양서류 DNA분양서비스
DNA분양서비스 동결건조서비스
동결건조서비스 STR분석서비스
STR분석서비스